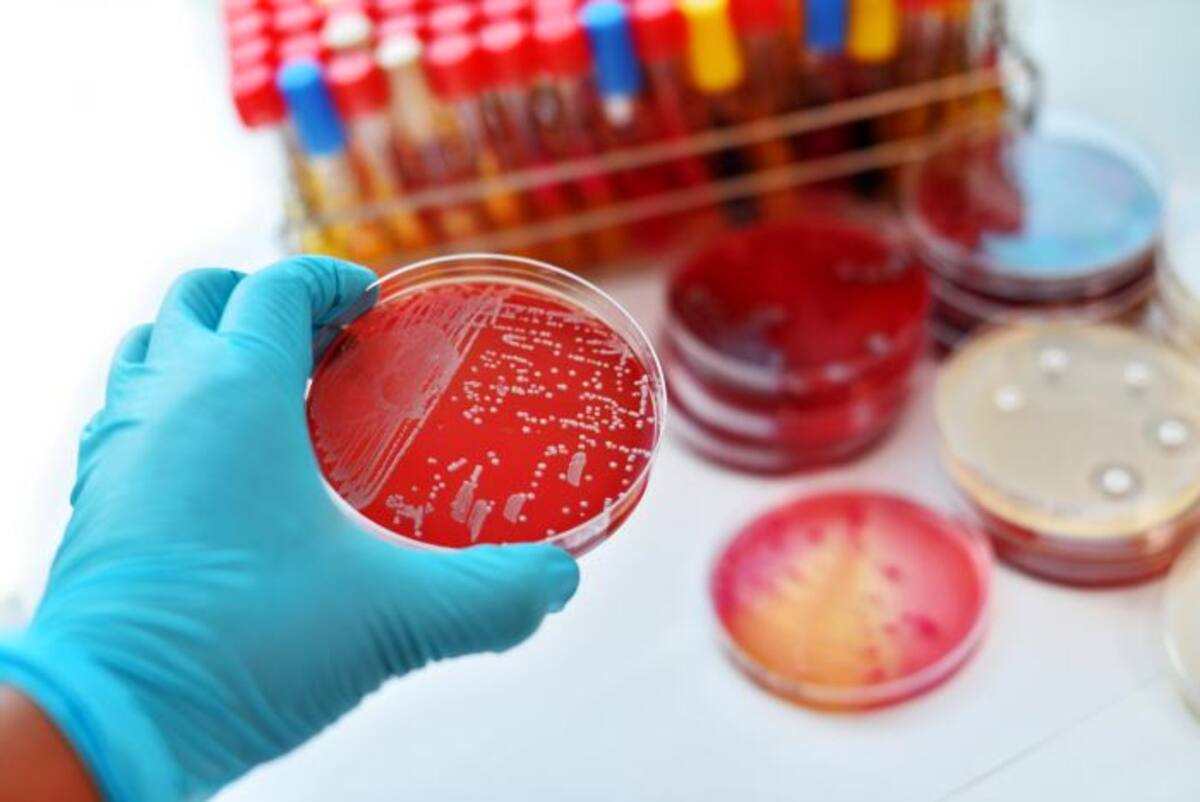
Las células madre se encuentran en la mayoría de los tejidos y órganos del cuerpo. 123rf

Los avances tecnológicos muchas veces requieren de un proceso de enseñanza para las personas, especialmente cuando están relacionados con la salud y la medicina, pues las personas piensan en un principio, en los posibles riesgos asociados, y el impacto que pueden tener en la salud.
Las células madre representan el avance más reciente en los tratamientos médicos pues se aprovecha el potencial regenerador del cuerpo para lograr la curación de enfermedades tradicionalmente complejas.
Las células madre son células no diferenciadas que les permite dependiendo de las necesidades del cuerpo, convertirse en células musculares, óseas, hepáticas, neuronas, o cualquier otro tipo de célula.
“Nadie quiere estar en una situación de vulnerabilidad, pero cuando un tratamiento médico como la terapia celular se empieza a aplicar en seres humanos es porque ha surtido una serie de pruebas que nos permiten afirmar que es seguro para las personas”, explica Andrea Becerra, directora científica de la clínica americana, BioXcellerator.
Por la novedad de este tipo de terapia, existen múltiples inquietudes y dudas al respecto, lo que ha dado pie a algunos mitos que es importante desmentir pues desvirtúan los beneficios reales de la terapia celular.
Mito: la terapia celular es tratamiento genético o clonación
La experta cuenta que uno de los principales mitos que hay alrededor de las células madre es que implican tratamiento genético, e incluso clonación, lo cual no es del todo cierto, pues, si bien las células madre pueden ser insumo para realizar algún procedimiento genético, el tratamiento celular no tiene que ver con este manejo de las células. La terapia en sí consiste en cultivar las células en el laboratorio para incentivar su reproducción, pues el cuerpo pierde, con la edad, la capacidad de generar nuevas células madre, de acuerdo con eso, la terapia celular no busca copiar las células que es lo que hace la clonación.
Mito: la terapia celular es la solución a todas las enfermedades
“Uno de los aspectos más notorios del desconocimiento del tratamiento se da cuando muchas personas creen que la terapia celular será la solución para todas las enfermedades; si bien es una realidad que esta tecnología ha representado avances significativos para diversos males, no es una solución milagrosa y para muchas enfermedades aún estamos en proceso de aprendizaje, no solo desde la terapia celular, sino desde la misma medicina”, expresó Karolynn Halpert, directora médica de BioXcellerator.
Mito: la terapia celular ocasiona cáncer
Otro de los asuntos más representativos es la creencia de que inyectar células madre incentiva la aparición de cáncer, lo cual es falso ya que, hasta la fecha, no se ha reportado ningún proceso tumoral ocasionado por el tratamiento celular, “lo que sucede es que alrededor de esta nueva alternativa hay mucho desconocimiento entre las personas, por lo que es importante realizar labores pedagógicas que acerquen esta nueva tecnología a la cotidianidad”, explicó Andrea.
Mito: la terapia celular genera rechazo por parte del cuerpo
Por otra parte, se ha difundido la idea de que las células madre inyectadas son atacadas por el sistema inmunitario del paciente, es decir genera rechazo, situación que no corresponde a la realidad pues este tipo de células al momento de comenzar el tratamiento, no se han diferenciado en algún tipo específico de célula, es decir, son neutrales, por lo que no activan agentes que generen reacciones contrarias que generen algún riesgo para el paciente.
Esto se da, en parte, porque, a diferencia de lo que se cree, las células madre no vienen exclusivamente de los embriones, sino que están presentes en todos los tejidos y órganos, principalmente en la grasa, médula ósea, sangre, cordón umbilical, placenta, líquido amniótico, dientes, entre otros.
“Queremos que las personas aprendan más acerca de este procedimiento pues es el próximo paso de la medicina: tomamos el poder regenerador de tu propio cuerpo para sanar tus enfermedades, y esto se logra gracias a la implementación de alta tecnología médica, la cual ha demostrado la efectividad en pacientes de distintas enfermedades como Alzheimer, Parkinson, Diabetes, entre otras”, finalizó Karolynn.